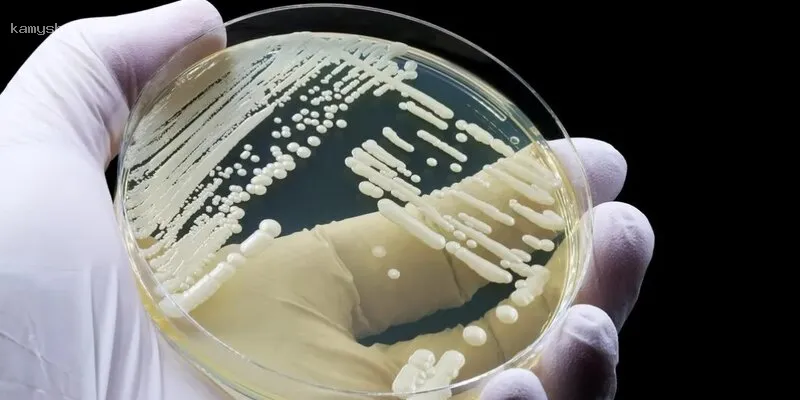
В Китае ученые выявили новый грибок-мутант, способный привести человека к гибели

Китайские микробиологи рассказали о новом смертельно опасном грибке-мутанте
При повышении температуры грибок начинает мутировать с огромной скоростью, становясь все более агрессивным. Темпы его мутации при 37 градусах (температура тела человека) оказались в 21 раз выше, чем при комнатной температуре.

В научном журнале Nature Microbiology китайские ученые рассказали о новом опасном грибке-мутанте, заражение которым может привести к летальному исходу.
Во время исследования микробиологи изучили образцы различных грибков, которые были взяты у пациентов, лечившихся в разных регионах Китая за период 2009- 2019 г.г. Из собранных проб две – особо заинтересовали ученых: в них содержался неизвестный ранее грибок, который получил название Rhodosporidiobolus fluvialis.
Один такой образец был взят у 61-летнего пациента, лечившегося в нанкинской больнице в 2013 году, другой - у 85-летнего пациента, который в 2016 году попал в реанимацию в Тяньцзине. Оба мужчины, заразившись этим грибком, погибли. Rhodosporidiobolus fluvialis оказался стойким к таким популярным противогрибковым препаратам, как флуконазол и каспофунгин, которыми пациентов пытались лечить.
Исследователи экспериментировали с неизвестным грибком, используя лабораторных мышей с ослабленным иммунитетом. При этом они обнаружили, что при повышении температуры грибок начинает мутировать с огромной скоростью, становясь все более агрессивным. Темпы его мутации при 37 градусах (температура тела человека) оказались в 21 раз выше, чем при комнатной температуре.
Ранее сообщалось о создании в Китае препарата, который способен более эффективно, чем антибиотики, противостоять инфекциям.

Новые комментарии